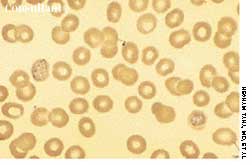

Four days after having been given cefuroxime for sinusitis, a 49-year-old woman experienced abdominal cramping, diarrhea, fever (temperature of 39.4°C [103°F]), and nausea. These problems persisted for 1 week, at which time the patient arrived at the emergency department. She had no recent history of travel, ingestion of undercooked food, or exposure to anyone with similar digestive problems.